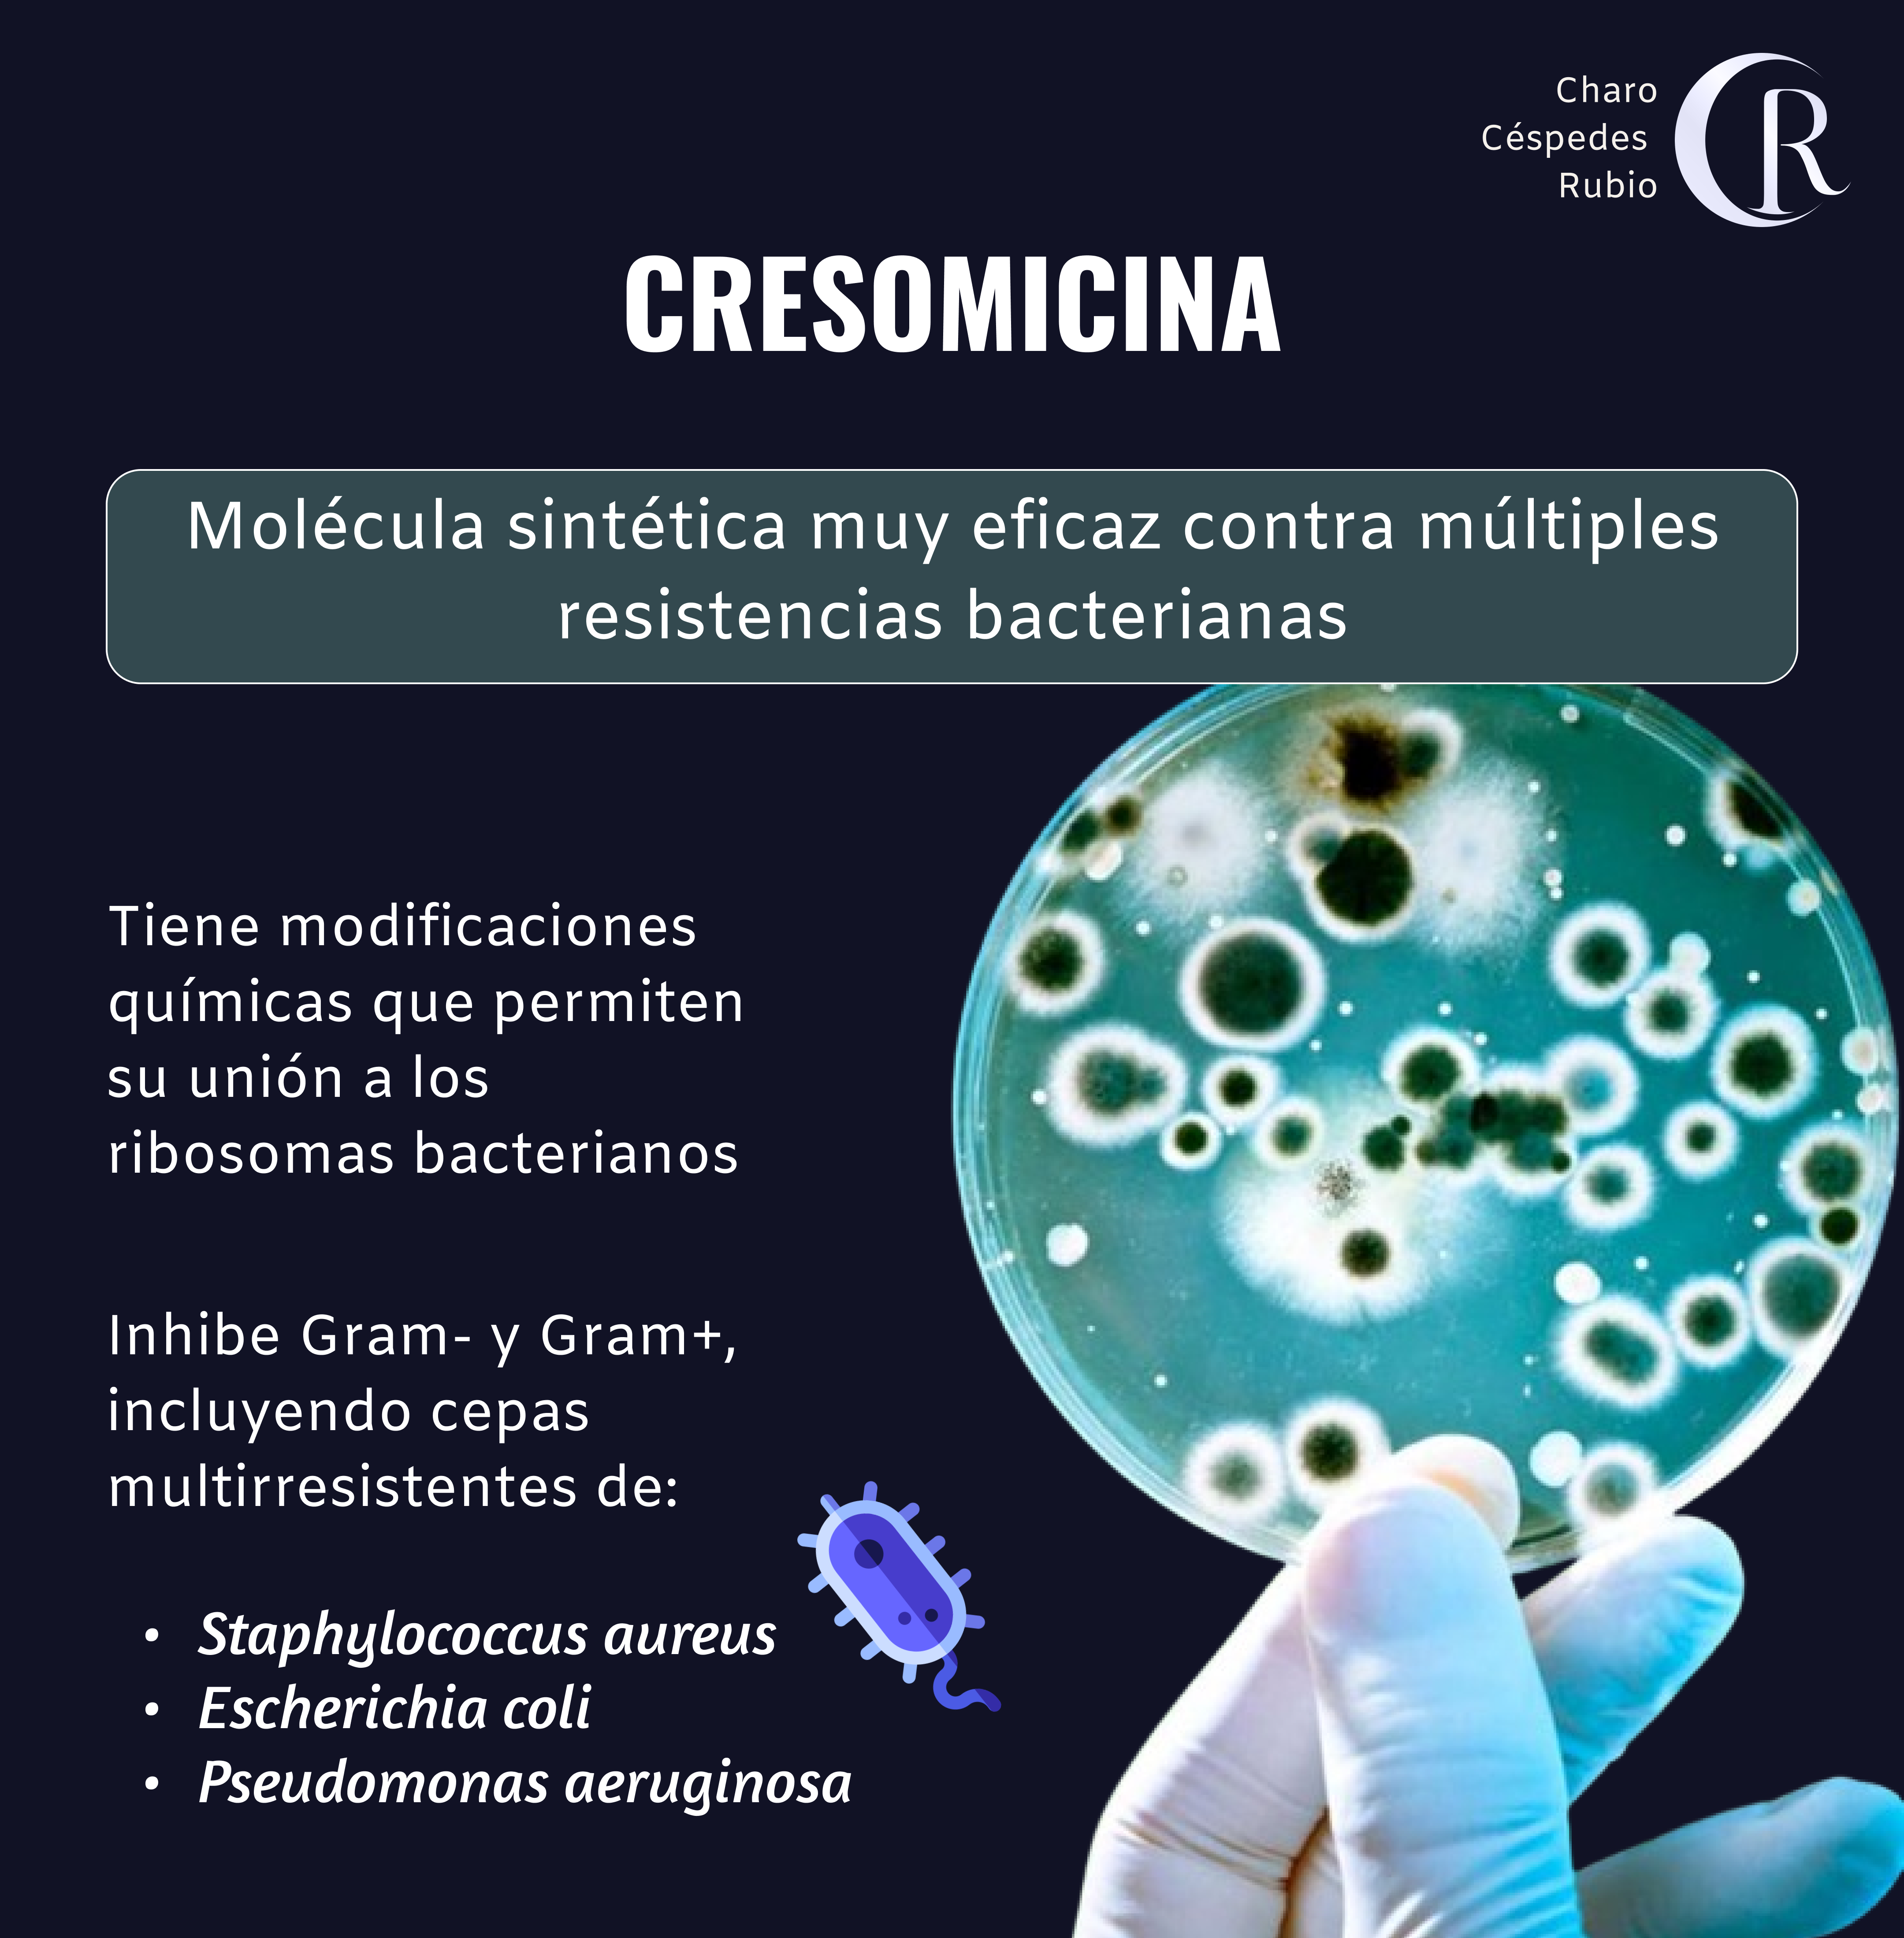

Microbiología
Cresomicina: nuevo antibiótico eficaz contra las bacterias resistentes

Charo Céspedes Rubio
Biología | Bacteriología y Laboratorio Clínico | Microbiología Clínica
31 oct 2024
Las resistencias son mecanismos de protección creados por algunas bacterias que impiden que los medicamentos tradicionales funcionen.
Algunos antibióticos actúan atacando a los ribosomas bacterianos y las bacterias contrarrestan este mecanismo de acción produciendo metiltransferasas de ARN ribosomal.
Estas enzimas modifican los ribosomas, impidiendo que los antibióticos se unan a ellos.
La cresomicina es un nuevo antibiótico creado por un equipo de investigadores de Harvard dirigido por Andrew Myers.
Es una molécula sintética que inhibe bacterias Gram-negativas y Gram-positivas, incluyendo cepas multirresistentes de Staphylococcus aureus, Escherichia coli, y Pseudomonas aeruginosa tanto in vitro como in vivo (ratones).
Aunque la seguridad y eficacia en humanos aún se desconocen, los resultados muestran una actividad inhibidora significativa en comparación con los antibióticos clínicamente aprobados.
Esta molécula se inspira en la estructura química de las lincosamidas, una clase de antibiótico semisintético.
La cresomicina es un antibiótico totalmente sintético y tiene modificaciones químicas que permiten se una a los ribosomas bacterianos aunque estén modificados por las metiltransferasas.